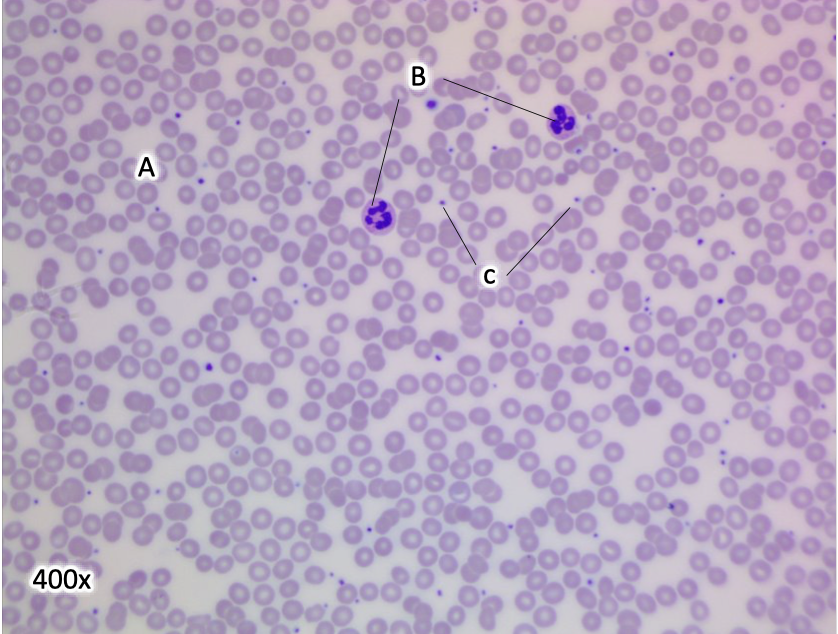
<p>A</p>

LAB 211 pt 1
1/150
There's no tags or description
Looks like no tags are added yet.
Name | Mastery | Learn | Test | Matching | Spaced | Call with Kai |
|---|
No analytics yet
Send a link to your students to track their progress
151 Terms
Pineal Gland
A

Hypothalamus
B

Pituitary Gland
C

Pituitary Anterior lobe
A

Pituitary Posterior lobe
B

Thyroid Gland
A

Parathyroid Gland
B

Pancreas
A

Adrenal Glands
B

Islet of Langerhans pancreas
A

Capsule
A

Zona glomerulosa
B

Zona fasciculata
C

Zona reticularis
D

Medulla
E

Ovary
A

Testis
B

Testis

Ovaries

Oocyte
*

Follicles
circles

seminiferous tubules
A

leydig cells
B

Erythrocytes
A
leukocytes
B

Platelets
C

granulocytes
neutrophil, eosinophil, basophil

agranulocytes
lymphocyte, monocyte

neutrophil

eosinophil

Basophil

lymphocyte

monocyte

Auricle of right atria
A

auricle of left atria
B

right coronary sulcus
C

left coronary sulcus
D

anterior interventricular sulcus
E

Apex
F

Superior vena cava
A

aorta
B

pulmonary trunk
C

left pulmonary artery
D

right pulmonary artery
E

Right coronary Artery
A

Anterior cardiac vein
B

left coronary artery
C

anterior interventricular artery
D

great cardiac vein
E blue vessel

Right Marginal vein
F

left pulmonary veins
A

right pulmonary veins
B

inferior vena cava
C

coronary sinus
D

middle cardiac vein
E

Posterior interventricular artery
F

Right coronary artery
G

Right atrium
A

Left atrium
B

Right ventricle
C

Left ventricle
D

fossa ovalis
E

pulmonary valve
F

aortic valve
G

tricuspid valve
H

mitral (bicuspid) valve
I

chordae tendineae
J

papillary muscles
K

interventricular septum
L

Superior vena cava
5

Pulmonary trunk
9

left Pulmonary artery
15

left pulmonary vein
16

right subclavian vein
46

right subclavian artery
47

thyrocervical trunk
48

aorta
A

Brachiocephalic trunk
B

Left common carotid artery
C

left subclavian artery
S

Left subclavian vein
D

Left subclavian artery
E

Right Brachiocephalic vein
F

Left brachiocephalic vein
G

Right common carotid artery
H

Right pulmonary artery
I

Right pulmonary vein
J

Common carotid artery
34

internal carotid artery
35

external carotid artery
36

superior thyroid artery
37

lingual artery
38

facial artery
39

occipital artery
40

posterior auricular artery
41

maxillary artery
42

superficial temporal artery
43

internal jugular vein
44

external jugular vein
45

inferior thyroid artery
49
